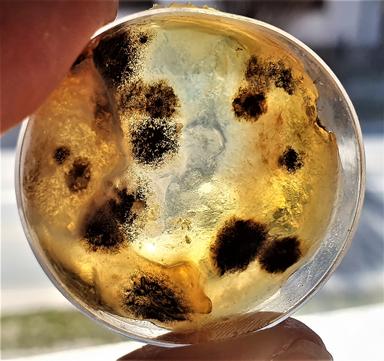
Istraživački rad - Koje je sredstvo najdjelotvornije u borbi protiv raznih mikroorganizama?

Svi materijali
Broj rezultata:35675
Vrsta obrazovnog sadržaja
Format materijala
Kome je materijal namijenjen
Kategorije
Obrazovni sadržaji
Informativni i dokumentarni sadržaji
Materijali
Broj prikazanih stavki: 10
Odaberite poredak

Klime na Zemlji
Josipa Zanki
Obrazovni sadržaji • Osnovne škole
Uređeno prije: 41mj
1

Geografska raznolikost Hrvatske - ppt
Josipa Zanki
Obrazovni sadržaji • Osnovne škole • 5. razred
Uređeno prije: 26mj
1
Istraživački rad za učenike koji imaju poteškoće u učenju.
Sanja Grbeš
Didaktičko-metodičke upute za učenike s posebnim odgojno-obrazovnim potrebama
Obrazovni sadržaji • Osnovne škole • 7. razred • Biologija
DOCX
Istraživački rad - Koje je sredstvo najdjelotvornije u borbi protiv raznih mikroorganizama? Kruh kao hranjiva podloga
Sanja Grbeš
Obrazovni sadržaji • Osnovne škole • 7. razred • Biologija
Istraživački rad - Koje je sredstvo najdjelotvornije u borbi protiv raznih mikroorganizama?
Sanja Grbeš
Obrazovni sadržaji • Osnovne škole • 7. razred • Biologija
Applied Digital Skills (Primijenjene digitalne vještine) - Googleov kurikulum digitalne pismenosti
Vjera Barbir Alavanja
Scenarij poučavanja
Obrazovni sadržaji • Cjeloživotno učenje • Digitalno građanstvo
Uređeno prije: 26mj
1
Korelacija informatike i tjelesne i zdravstvena kulture
Majdi Pamuković
Scenarij poučavanja za međupredmetne teme
Obrazovni sadržaji • Osnovne škole
PPTX

Halloween crossword
Irena Ines Orak
Obrazovni element
Obrazovni sadržaji • Srednje škole - opći predmeti
DOCX

Halloween wordsearch
Irena Ines Orak
Tekst
Obrazovni sadržaji • Srednje škole - opći predmeti
DOCX
Christmas crossword GIGANTIC
Irena Ines Orak
Tekst
Obrazovni sadržaji • Srednje škole - opći predmeti
DOCX